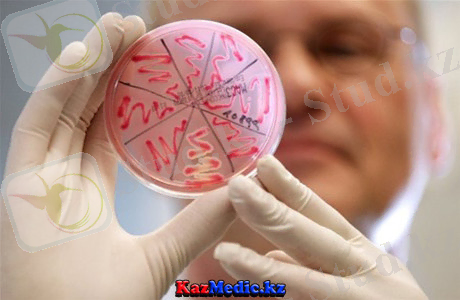
ÐÐ°ÑÑÐ¸Ð½ÐºÐ¸ Ð¿Ð¾ Ð·Ð°Ð¿ÑÐ¾ÑÑ ÐºÐ»ÐµÐ±ÑÐ¸ÐµÐ»Ð»Ð°Ð»Ð°Ñ

Клебсиеллалардың патогендігі, экологиясы және ауруханаішілік инфекциялардың дамуындағы рөлі: лабораториялық анықтау, алдын алу және емдеу


Марат Оспанов атындағы Батыс Қазақтан Мемлекеттік медицина университеті

«Студенттің өзіндік жұмысы»
Тақырыбы: Клебсиеллалар патогенділігі. Этиологиялық, патогендік ролі. Экологиясы. Ауруханаішілік инфекция дамуындағы ролі. Лабораториялық анықтауы. Алдын алу және емдеу.
Мамандығы: Жалпы медицина
Пәні: Микробиология
Курс: 2
Орындалу түрі: МӘНЖАЗБА
Орындаған: Жамангулов Ж. Т.
Группа: 202 Б
Тексерген: Мусабаева С . Ж.
АҚТӨБЕ 2018 жыл
ЖОСПАР
І. Кіріспе
ІІ. Негізгі бөлім:
- Түрлері
- Морфологиясы
- Дақылды өсіру
- Ферменттік белсенділігі
- Антигендік құрылымы
- Экологиясы мен эпидемиологиясы.
- Патогенез және клиникасы.
- Иммунитеті
- Диагнстикасы
- Сақтандыруы және емдеуі.
ІІІ. Қорытынды
IV. Пайдаланылған әдебиеттер
Кіріспе:
Клебсиеллалар (Klebsiella туыстастығы) .
Бактерияның аталуы і875 жылы алғаш рет ашқан Heміс бактериологы Э. Клебс атымен байланысты. Klebsiella туыстастығына бірнеше түрлер кіреді. Klebsiella pneumoniae, K. oxytoca, K. mobilis, K. planticola, K. terrigena, бip-бipiнeн биохимиялық қасиеттері бойынша ажыратылады. Адамға патогенді Tүpi Klebsiella pneumoniae, үш түрастына бөледі. Klebsiella pneumoniae subsp. pneumoniae, Klebsiella pneumoniae subsp. ozaenae, Klebsiella pneumoniae subsp. rhinoscleromatis, Соңғы жылдары жаңа клебсиелла түрлері анықталған (K. oxytocа mobilis, K. planticola, K. terrigena), олардың адам патологиясындағы рөлі анықталуда. Клебсиеллалар адамның және жануардың тepiciндe, кілегей қабығында барлық уақытта кездеседі. Klebsiella pneumoniae -ауруханаішілік инфекциялардың маңызды қоздырғышы.
Морфологиясы.
Клебсиеллалар - грам тepic, uienepi жұмырланган, қысқа таяқшалар, мөлшері өте құбылмалы. Ерекше морфологиялық белгісі- капсула. Талшықтары, спорасы жоқ, кейбір штамдарда кірпікшелері бар. Көбінесе калың полисахариде капсуласын көруге болады. Жағындыда бip-бipeyдeн, жұптасып немесе қысқа тізбектеліп орналасады.

Дақылды өcipy.
Клебсиеллалар қарапайым қоректік орталарда жақсы өceдi, факультативе анаэробтар, хемоорганотрофтар. Оптимальді өсу температурасы 35-37°С, рН 7. 2-7. 4. Симмонс қоректік ортасында өседі, яғни цитрат натрийді көмipcyтeгi көзi ретінде қолданады. Тығыз қоректік ортада күмбез тәрізді, бұлынғыр, кілейгелі колониялар түзеді, сонымен қатар. Ет-пептонды сорпада клебсиеллалар органы толығымен лайландырады, кейбір кезде бетінде кілейгейлі қабықша пайда болады; жартылай сұйық ортаның бетінде жақсы көбейеді.
Биохимиялық белсенділігі.
Клебсиеллалар көмірсуларды ыдыратады, нитратты нитритке айналдырады. Желатинді ыдыратпайды, индол, күкірт сутегін түзбейді. Уреазалыық белсенділігі бар, сүтті ipiтпейді.
Антигендік кұрылымы.
Клебсиеллаларды О- және К-Антигендері бар. О-антигендері бойынша 11 серологиялық топтары шықталған, К-антигендері бойынша - 82. Клебсиеллалардың . серологиялық варианттарын анықтауы К-антигендерін ажыратуымен шектеледі. Kейбip клебсиеллалардың К-антигендері эшерихиялардың және салмонеллалардың К-антигендеріне туыстас болып келеді
Патогенді факторлары.
Клебсиеллалардың нeгiзгi патогенді факторлары К-антиген (фагоцитозды тежейді) және эндотоксин. Сонымен қатар, термолабилді және термостабилді энтеротоксин үзеді, әсер ету механизмі мен ақуыздар құрылысы бойынша энтеротоксигенді iшек таяқшасының токсиніне ұқсас келеді. Клебсиеллалардың адгезивтік қасиеті жоғары (маннозаресзистентті фимбриялар) . Вируленттік ферменттертүзеді: ДНҚаза, нейраминидаза, фосфатаза.
Клебсиелла туыстығына жататын бактериялардың
биохимиялық қacиeттepi
KapceTKiurrepi
K. oxvtoca
K. pneumoniae
ozaenae
pneumoniae
rhinoscleroniatis
Индол түзңлуі
+
-
-
-
Метил рот реакциясы
+/-
+
-
-
Фогес-Проскауэр реакциясы
+
-
+
-
Цитраттың утилнзациясы
+
+/-
+
-
Малоиаттың утилнзациясы
+
+/-
+
-
Мочевинаны ыдыратуы
+
+/-
+
-
Лизиндекарбоксилаза
+
+/-
+
-
Лактозаны ыдыратуы
+
+/-
+
-
Экологиясы мен эпидемиологиясы.
Ішек, жоғары тынық жолдары, қынаптың факултативті микрофлорасының құрамына кіреді. Капсуласына байланысты қоршаған орта факторларына тұрақты және топырақта, суда, бөлмелерде көп уақыт сакталуы мүмкін.
Клебсиеллалық инфекция - көбінесе ауруханаішілік ауру. Инфекция көзi - науқас адам мен бактерия тасымалдаушы. Экзогенді және эндогенді жұктырулар кездеседі. Жұғу жолдары - тағам, ауа-тамшы және тұрмыстық қарым-қатынас арқылы. Негізгі жұқтыру факторлары - тағамдар (әcipece, ет және сүт тағамдары), су, ауа. Соңғы жылдары өсуде қоздырғыштың патогендік қасиеттерінің күшеюіне және адам ағзасының резистенттілігінің төмендеуіне байланысты клебсиеллез саны көбейе бастады. Сонымен қатар, клебсиеллалар антибиотиктерге сезімталдығының төмен болуымен сипатталады.
Клебсиеллалар түрлі дезинфектанттар әсеріне сезімтал, 65°С қыздырғанда бip сағат ішінде өледі қоршаған ортаға төзімді кілейгейлі капсула қоздырғышты құрғаудан сақтайды, сондықтан клебсиеллалар топырақта, аурухана бөлмелерінің шаңында, жиһаздарда көптеген апта және айлап сақталады.
Патогенез және клиникасы.
Klebsiella pneumoniae көптеген жағдайда iшек инфекциясына ұқсас дамиды және жылдам басталады, лоқсу, құсу, iштің ауырсынуы, диарея, қызба, жалпы әлсіздік байқалады, Ауру ұзактығы -1-5 күн. Клебсиеллалар тыныс алу мүшелерін буындарды, ми қабаттарын, коньюнктиваны, несеп шығару мүшелерін зақымдайды, және сепсис пен ipiңдi аскынулар тудырады. Аурудың ауыр түpi генерализацияланған септико-пнемиялық үpдic дамуы өлімге . әкеледі.
Klebsiella pneumoniae subsp. pneumoniae кептеген факторларға (дәрілерге) тұрақтылыққа ие, сондыктан қaзipгi уақытта ауруханаішілік инфекциялар қоздырғыштары ішінде алдыңғы қатарында тұрады, тыныс және зәр шығару жолдарын зақымдайды.

Klebsiella pneumoniae subsp. ozaenae мұрынның және мұрын қуыстарының кілейгел қабықтарын зақымдайды, олардың атрофиясы дамиды, кабыну ypдici барысында жағымсыз иіс беретін сұйықтық бөлінулерімен сипатталады.

Klebsiella pneumoniae subsp. rhinoscleromatis мурынның кілегей қабатын зақымдауымен бipre, көмей, бронх, жұтқыншақты да закымдайды, сонымен бipгe зақымдалған тіндерде арнайы гранулемалар түзіледі, олар склерозданып шеміршек тәpiздi инфильтратқа айналады. Ауру созылмалы турде өтеді .
K. oxytoca урологиялық клиникада ауруханаішілік инфекциялар тудырады.

Иммунитеті.
Инфекциядан кейін дамитын иммунитет тұрақты емес, негізінде жасушалық. Инфекцияға қарсы турудың нeгiзгi факторы фагоцитоз. Созылмалы түрінде гиперсезімталдыктың баяу типі дамиды.
Микробиологиялық диагностикасы.
... жалғасы- Іс жүргізу
- Автоматтандыру, Техника
- Алғашқы әскери дайындық
- Астрономия
- Ауыл шаруашылығы
- Банк ісі
- Бизнесті бағалау
- Биология
- Бухгалтерлік іс
- Валеология
- Ветеринария
- География
- Геология, Геофизика, Геодезия
- Дін
- Ет, сүт, шарап өнімдері
- Жалпы тарих
- Жер кадастрі, Жылжымайтын мүлік
- Журналистика
- Информатика
- Кеден ісі
- Маркетинг
- Математика, Геометрия
- Медицина
- Мемлекеттік басқару
- Менеджмент
- Мұнай, Газ
- Мұрағат ісі
- Мәдениеттану
- ОБЖ (Основы безопасности жизнедеятельности)
- Педагогика
- Полиграфия
- Психология
- Салық
- Саясаттану
- Сақтандыру
- Сертификаттау, стандарттау
- Социология, Демография
- Спорт
- Статистика
- Тілтану, Филология
- Тарихи тұлғалар
- Тау-кен ісі
- Транспорт
- Туризм
- Физика
- Философия
- Халықаралық қатынастар
- Химия
- Экология, Қоршаған ортаны қорғау
- Экономика
- Экономикалық география
- Электротехника
- Қазақстан тарихы
- Қаржы
- Құрылыс
- Құқық, Криминалистика
- Әдебиет
- Өнер, музыка
- Өнеркәсіп, Өндіріс
Қазақ тілінде жазылған рефераттар, курстық жұмыстар, дипломдық жұмыстар бойынша біздің қор #1 болып табылады.



Ақпарат
Қосымша
Email: info@stud.kz